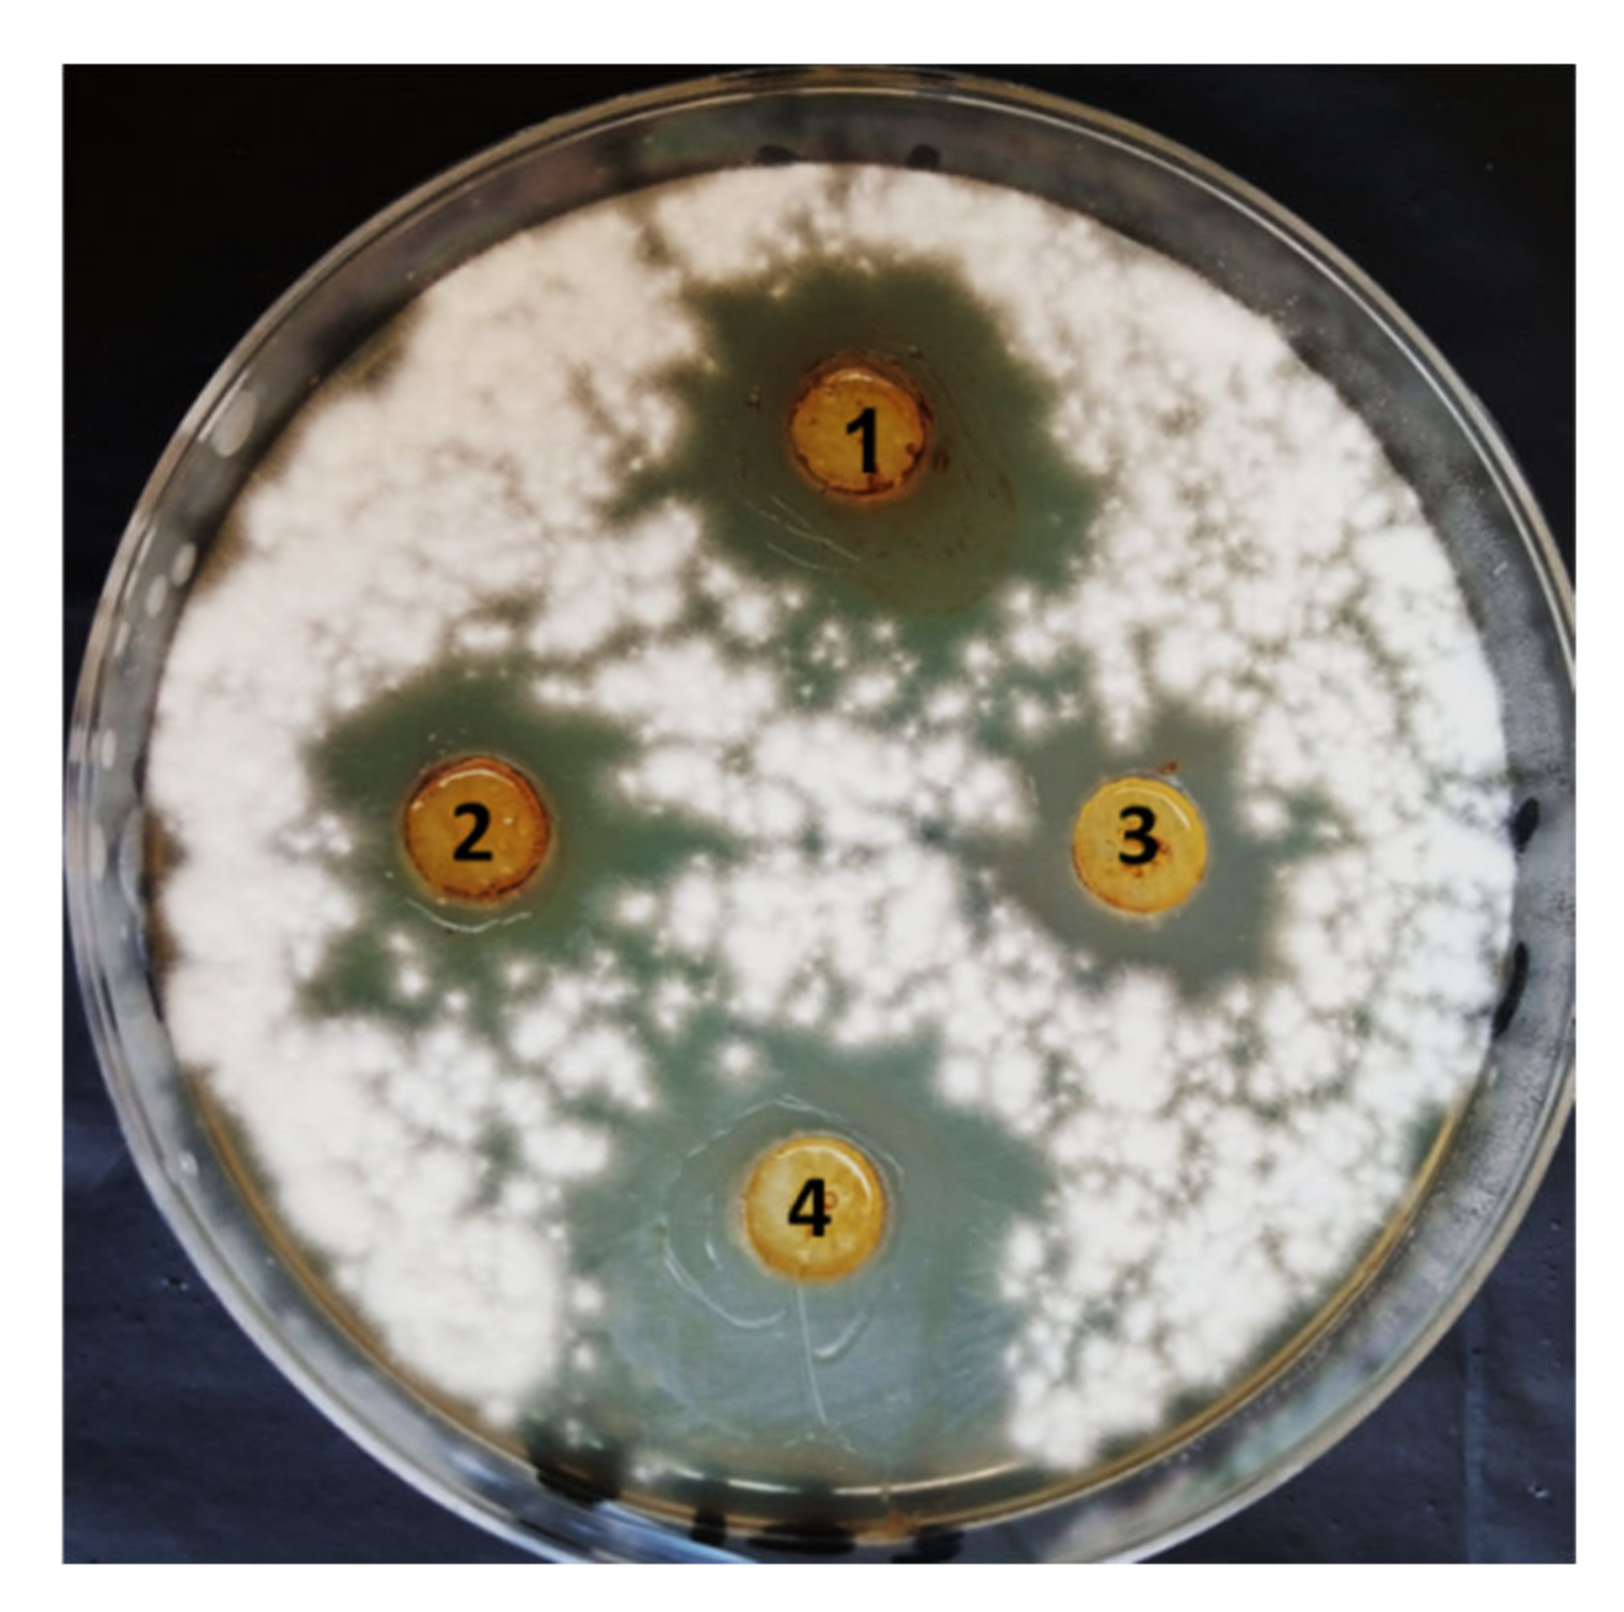
Jof 08 00775 g002 550

Plant Growth-Promoting Fungi as Biocontrol Tool against Fusarium Wilt Disease of Tomato Plant
Abstract
:1. Introduction
2. Materials and Methods
2.1. Tomato Plant
2.2. Source and Maintenance of the Pathogen
2.3. Isolation and Identification of PGPF
2.4. Extraction of Fungal Metabolites Using Ethyl Acetate
2.5. In Vitro Antifungal Activity of PGPF
2.6. In Vivo Study
2.7. Disease Severity and Percentage the Protection
2.8. Resistance Indicators
2.9. Isozymes Electrophoresis
2.10. Statistical Analyses
3. Results
3.1. Molecular Identification of PGPF
3.2. In Vitro Antifungal Activity of PGPF Strains against F. oxysporum
3.3. Estimation of Tomato Systemic Resistance Induced by PGPF against Fusarium Wilt
3.3.1. Disease Severity (DS) and Protection%
3.3.2. Growth Indicators
3.3.3. Photosynthetic Pigment
3.3.4. Physiological and Metabolic Changes
3.3.5. Isozymes
4. Discussion
5. Conclusions
Author Contributions
Funding
Institutional Review Board Statement
Informed Consent Statement
Data Availability Statement
Acknowledgments
Conflicts of Interest
References
- O’Connell, S.; Rivard, C.; Peet, M.M.; Harlow, C.; Louws, F. High Tunnel and Field Production of Organic Heirloom Tomatoes: Yield, Fruit Quality, Disease, and Microclimate. HortScience 2012, 47, 1283–1290. [Google Scholar] [CrossRef] [Green Version]
- Pramanik, K.; Mohapatra, P.P. Role of auxin on growth, yield and quality of tomato-A review. Int. J. Curr. Microbiol. Appl. Sci. 2017, 6, 1624–1636. [Google Scholar] [CrossRef]
- Boccia, F.; Boccia, F.; Di Donato, P.; Covino, D.; Poli, A. Food waste and bio-economy: A scenario for the Italian tomato market. J. Clean. Prod. 2019, 227, 424–433. [Google Scholar] [CrossRef]
- Ramakrishna, W.; Yadav, R.; Li, K. Plant growth promoting bacteria in agriculture: Two sides of a coin. Appl. Soil Ecol. 2019, 138, 10–18. [Google Scholar] [CrossRef]
- Tsitsigiannis, D.I.; Dimakopoulou, M.; Antoniou, P.P.; Tjamos, E.C. Biological control strategies of mycotoxigenic fungi and associated mycotoxins in Mediterranean basin crops. Phytopathol. Mediterr. 2012, 51, 158–174. [Google Scholar]
- Kumar, R.; Kumar, R.; Prakash, O. Chapter-5 the Impact of Chemical Fertilizers on Our Environment and Ecosystem. Chief Ed 2019, 35, 69. [Google Scholar]
- Dayarathne, M.C.; Mridha, A.U.; Wang, Y. Diagnosis of Fungal Plant Pathogens Using Conventional and Molecular Approaches. In Diagnostics of Plant Diseases; IntechOpen: London, UK, 2021. [Google Scholar] [CrossRef]
- Niu, B.; Wang, W.; Yuan, Z.; Sederoff, R.R.; Sederoff, H.; Chiang, V.L.; Borriss, R. Microbial Interactions Within Multiple-Strain Biological Control Agents Impact Soil-Borne Plant Disease. Front. Microbiol. 2020, 11, 585404. [Google Scholar] [CrossRef]
- Kang, Y.; Khan, S.; Ma, X. Climate change impacts on crop yield, crop water productivity and food security–A review. Prog. Nat. Sci. 2009, 19, 1665–1674. [Google Scholar] [CrossRef]
- Mancini, V.; Romanazzi, G. Seed treatments to control seedborne fungal pathogens of vegetable crops. Pest Manag. Sci. 2013, 70, 860–868. [Google Scholar] [CrossRef]
- Alamri, S.A.; Hashem, M.; Mostafa, Y.S.; Nafady, N.A.; Abo-Elyousr, K.A. Biological control of root rot in lettuce caused by Exserohilum rostratum and Fusarium oxysporum via induction of the defense mechanism. Biol. Control 2018, 128, 76–84. [Google Scholar] [CrossRef]
- Faheed, F.A.; Abd-Elaah, G.A.; Mazen, A. Alleviation of disease effect on tomato plants by heat shock and salicylic acid infected with Alternaria solani. Int. J. Agric. Biol. 2005, 7, 783–789. [Google Scholar]
- Selim, M.E.; El-Gammal, N.A. Role of Fusaric Acid Mycotoxin in Pathogensis Process of Tomato Wilt Disease Caused by Fusarium oxysporum. J. Bioprocess. Biotech. 2015, 5, 1. [Google Scholar] [CrossRef] [Green Version]
- Mandal, S.; Mallick, N.; Mitra, A. Salicylic acid-induced resistance to Fusarium oxysporum f. sp. lycopersici in tomato. Plant Physiol. Biochem. 2009, 47, 642–649. [Google Scholar] [CrossRef]
- Khan, A.; Singh, J.; Upadhayay, V.K.; Singh, A.V.; Shah, S. Microbial biofortification: A green technology through plant growth promoting microorganisms. In Sustainable Green Technologies for Environmental Management; Springer: Singapore, 2019; ISBN 9789811327728. [Google Scholar]
- Etesami, H.; Maheshwari, D.K. Use of plant growth promoting rhizobacteria (PGPRs) with multiple plant growth promoting traits in stress agriculture: Action mechanisms and future prospects. Ecotoxicol. Environ. Saf. 2018, 156, 225–246. [Google Scholar] [CrossRef]
- Moisan, K.; Cordovez, V.; van de Zande, E.M.; Raaijmakers, J.M.; Dicke, M.; Lucas-Barbosa, D. Volatiles of pathogenic and non-pathogenic soil-borne fungi affect plant development and resistance to insects. Oecologia 2019, 190, 589–604. [Google Scholar] [CrossRef] [Green Version]
- Sorokan, A.; Cherepanova, E.; Burkhanova, G.; Veselova, S.; Rumyantsev, S.; Alekseev, V.; Mardanshin, I.; Sarvarova, E.; Khairullin, R.; Benkovskaya, G.; et al. Endophytic Bacillus spp. as a prospective biological tool for control of viral diseases and non-vector Leptinotarsa decemlineata Say. in Solanum tuberosum L. Front. Microbiol. 2020, 11, 2433. [Google Scholar] [CrossRef]
- Kuźniar, A.; Włodarczyk, K.; Wolińska, A. Agricultural and Other Biotechnological Applications Resulting from Trophic Plant-Endophyte Interactions. Agronomy 2019, 9, 779. [Google Scholar] [CrossRef] [Green Version]
- Abdel-Motaal, F.; Kamel, N.; El-Zayat, S.; Abou-Ellail, M. Early blight suppression and plant growth promotion potential of the endophyte Aspergillus flavus in tomato plant. Ann. Agric. Sci. 2020, 65, 117–123. [Google Scholar] [CrossRef]
- Yaldiz, G.; Camlica, M. Impact of Various Environmental Stress Factors on Productivity, Quality, and Secondary Metabolites of Fenugreek (Trigonella foenum-graecum L.). Fenugreek 2021, 301–326. [Google Scholar] [CrossRef]
- Koorapati, R. Comparison of Vegetable and Animal Peptone-Based Culture Media for Detection of Salmonella in Poultry. Ph.D. Thesis, UNSW Sydney, Sydney, Australia, 2010. [Google Scholar]
- Kour, D.; Rana, K.L.; Yadav, A.N.; Yadav, N.; Kumar, M.; Kumar, V.; Vyas, P.; Dhaliwal, H.S.; Saxena, A.K. Microbial biofertilizers: Bioresources and eco-friendly technologies for agricultural and environmental sustainability. Biocatal. Agric. Biotechnol. 2019, 23, 101487. [Google Scholar] [CrossRef]
- Glick, B.R. Plant Growth-Promoting Bacteria: Mechanisms and Applications. Scientifica 2012, 2012, 963401. [Google Scholar] [CrossRef] [Green Version]
- Abdelaziz, A.M. Inhibition of Aspergillus flavus Growth and Aflatoxin Production in Zea mays L. Using Endophytic Aspergillus fumigatus. J. Fungi 2022, 8, 482. [Google Scholar] [CrossRef]
- Mohammed, B.L.; Hussein, R.A.; Toama, F.N. Biological control of Fusarium wilt in tomato by endophytic rhizobactria. Energy Procedia 2019, 157, 171–179. [Google Scholar] [CrossRef]
- Farrag, A. Potential impacts of elicitors to improve tomato plant disease resistance. Al Azhar Bull Sci. 2017, 9, 311–321. [Google Scholar]
- Attia, M.S.; Sherif, S.S.; Mansour, M.M.; Kandil, E.K. Eco-Friendly Inducers and Its Potential Impacts to Improve Pear Seedlings Bacterial Disease Resistance. J. Biotechnol. 2019, 59, 200–210. [Google Scholar]
- Beneduzi, A.; Ambrosini, A.; Passaglia, L.M. Plant growth-promoting rhizobacteria (PGPR): Their potential as antagonists and biocontrol agents. Genet. Mol. Biol. 2012, 35, 1044–1051. [Google Scholar] [CrossRef] [PubMed] [Green Version]
- El-Wakil, D. Antagonistic Effect of Plant Growth-Promoting Fungi Against Fusarium Wilt Disease in Tomato: In vitro and In vivo Study. Appl. Biochem. Biotechnol. 2022. [Google Scholar] [CrossRef]
- Choudhary, D.K.; Johri, B.N. Interactions of Bacillus spp. and plants–with special reference to induced systemic resistance (ISR). Microbiol. Res. 2009, 164, 493–513. [Google Scholar] [CrossRef]
- Hibar, K.; Steinberg, C.; Gautheron, N.; Alabouvette, C.; El Mahjoub, M.; Edel-Herman, V.; Daami-Remadi, M. Genetic Diversity of Fusarium oxysporum Populations Isolated from Tomato Plants in Tunisia. J. Phytopathol. 2007, 155, 136–142. [Google Scholar] [CrossRef]
- Alhakim, A.A.; Hashem, A.; Abdelaziz, A.M.; Attia, M.S. Impact of plant growth promoting fungi on biochemical defense performance of Tomato under Fusarial infection. Egypt. J. Chem. 2022. [Google Scholar] [CrossRef]
- Khalil, A.M.A.; Hashem, A.H.; Abdelaziz, A.M. Occurrence of toxigenic Penicillium polonicum in retail green table olives from the Saudi Arabia market. Biocatal. Agric. Biotechnol. 2019, 21, 101314. [Google Scholar] [CrossRef]
- Sathiyaseelan, A.; Saravanakumar, K.; Mariadoss, A.V.A.; Kim, K.M.; Wang, M.-H. Antibacterial activity of ethyl acetate extract of endophytic fungus (Paraconiothyrium brasiliense) through targeting dihydropteroate synthase (DHPS). Process Biochem. 2021, 111, 27–35. [Google Scholar] [CrossRef]
- Dacrory, S.; Hashem, A.H.; Hasanin, M. Synthesis of cellulose based amino acid functionalized nano-biocomplex: Characterization, antifungal activity, molecular docking and hemocompatibility. Environ. Nanotechnol. Monit. Manag. 2021, 15, 100453. [Google Scholar] [CrossRef]
- Vernon, L.P.; Seely, G.R. The Chlorophylls; Academic Press: Cambridge, MA, USA, 2014. [Google Scholar]
- Lowry, O.H.; Rosebrough, N.J.; Farr, A.L.; Randall, R.J. Protein measurement with the Folin phenol reagent. J. Biol. Chem. 1951, 193, 265–275. [Google Scholar] [CrossRef]
- Irigoyen, J.; Sánchez-Díaz, D.E.M. Water stress induced changes in concentrations of proline and total soluble sugars in nodulated alfalfa (Medicago sativd) plants. Physiol. Plant. 1992, 84, 55–60. [Google Scholar] [CrossRef]
- Bates, L.S.; Waldren, R.P.; Teare, I.D. Rapid determination of free proline for water-stress studies. Plant Soil 1973, 39, 205–207. [Google Scholar] [CrossRef]
- Matta, A.; Dimond, A. Symptoms of Fusarium wilt in relation to quantity of fungus and enzyme activity in tomato stems. Phytopathology 1963, 53, 574–584. [Google Scholar]
- Srivastava, S.K. Peroxidase and Poly-Phenol Oxidase in Brassica juncea Plants Infected with Macrophomina phaseolina (Tassai) Goid. and their Implication in Disease Resistance. J. Phytopathol. 1987, 120, 249–254. [Google Scholar] [CrossRef]
- Barcelo, A.R.; Munoz, R.; Sabater, F. Lupin peroxidases. I. Isolation and characterization of cell wall-bound isoperoxidase activity. Physiol. Plant. 1987, 71, 448–454. [Google Scholar] [CrossRef]
- Thipyapong, P.; Hunt, M.D.; Steffens, J.C. Systemic wound induction of potato (Solanum tuberosum) polyphenol oxidase. Phytochemistry 1995, 40, 673–676. [Google Scholar] [CrossRef]
- Brownlee, K. Probit Analysis: A Statistical Treatment of the Sigmoid Response Curve; JSTOR: New York, NY, USA, 1952. [Google Scholar]
- Abdelaziz, A.M.; Salem, S.S.; Khalil, A.M.A.; El-Wakil, D.A.; Fouda, H.M.; Hashem, A.H. Potential of biosynthesized zinc oxide nanoparticles to control Fusarium wilt disease in eggplant (Solanum melongena) and promote plant growth. BioMetals 2022, 35, 601–616. [Google Scholar] [CrossRef]
- Snedecor, G.W.; Cochran, W.G. Statistical Methods, 2nd ed.; Iowa State University Press: Ames, IA, USA, 1982; p. 507. [Google Scholar]
- Hashem, A.; Abdelaziz, A.; Askar, A.; Fouda, H.; Khalil, A.; Abd-Elsalam, K.; Khaleil, M. Bacillus megaterium-Mediated Synthesis of Selenium Nanoparticles and Their Antifungal Activity against Rhizoctonia solani in Faba Bean Plants. J. Fungi 2021, 7, 195. [Google Scholar] [CrossRef]
- Khalil, A.M.; Ahmed, A.F.; Mahmoud, E.E.; Abdelaziz, A.M. Influence of Organic Farming System on Microbial Biomass and Fungal Communities of Agricultural Soil. Afr. J. Mycol. Biotechnol. 2015, 20, 23–40. [Google Scholar]
- Khalil, A.; Abdelaziz, A.; Khaleil, M.; Hashem, A. Fungal endophytes from leaves of Avicennia marina growing in semi-arid environment as a promising source for bioactive compounds. Lett. Appl. Microbiol. 2020, 72, 263–274. [Google Scholar] [CrossRef]
- Sharaf, M.H.; Abdelaziz, A.M.; Kalaba, M.H.; Radwan, A.A.; Hashem, A.H. Antimicrobial, Antioxidant, Cytotoxic Activities and Phytochemical Analysis of Fungal Endophytes Isolated from Ocimum Basilicum. Appl. Biochem. Biotechnol. 2021, 194, 1271–1289. [Google Scholar] [CrossRef]
- El-Maraghy, S.; Tohamy, A.; Hussein, K. Plant protection properties of the Plant GrowthPromoting Fungi (PGPF): Mechanisms and potentiality. Curr. Res. Environ. Appl. Mycol. 2021, 11, 391–415. [Google Scholar] [CrossRef]
- Murali, M.; Amruthesh, K.N. Plant Growth-promoting Fungus Penicillium oxalicum Enhances Plant Growth and Induces Resistance in Pearl Millet Against Downy Mildew Disease. J. Phytopathol. 2015, 163, 743–754. [Google Scholar] [CrossRef]
- Yin, Z.; Abdelaziz, A.M.; Kalaba, M.H.; Radwan, A.A.; Hashem, A.H. Phosphate solubilization and promotion of maize growth by Penicillium oxalicum P4 and Aspergillus niger P85 in a calcareous soil. Can. J. Microbiol. 2015, 61, 913–923. [Google Scholar] [CrossRef]
- Li, X.; Li, D.; Yan, J.; Zhang, Y.; Wang, H.; Zhang, J.; Ahmed, T.; Li, B. Effect of Plant-Growth-Promoting Fungi on Eggplant (Solanum melongena L.) in New Reclamation Land. Agriculture 2021, 11, 1036. [Google Scholar] [CrossRef]
- Galeano, R.M.S.; Franco, D.G.; Chaves, P.O.; Giannesi, G.C.; Masui, D.C.; Ruller, R.; Corrêa, B.O.; Brasil, M.D.S.; Zanoelo, F.F. Plant growth promoting potential of endophytic Aspergillus niger 9-p isolated from native forage grass in Pantanal of Nhecolândia region, Brazil. Rhizosphere 2021, 18, 100332. [Google Scholar] [CrossRef]
- Aldinary, A.M.; Abdelaziz, A.M.; Farrag, A.A.; Attia, M.S. Biocontrol of tomato Fusarium wilt disease by a new Moringa endophytic Aspergillus isolates. Mater. Today Proc. 2021. [Google Scholar] [CrossRef]
- Attia, M.S.; Younis, A.M.; Ahmed, A.F.; Elaziz, A.M.A. Comprehensive Management for Wilt Disease Caused By Fusarium Oxysporum in Tomato Plant. IJISET-Int. J. Innov. Sci. Eng. Technol. 2016, 4, 201. [Google Scholar]
- Chen, H.; Qi, Y.; He, X.; Xu, L.; Zhang, W.; Lv, X.; Zhang, H.; Yang, D.; Zhu, Y.; Liang, Z. Endophytic fungus Mucor circinelloides DF20 promote tanshinone biosynthesis and accumulation in Salvia miltiorrhiza root. Plant Sci. 2021, 307, 110898. [Google Scholar] [CrossRef] [PubMed]
- Ismail, Aspergillus Flavus Promoted the Growth of Soybean and Sunflower Seedlings at Elevated Temperature. BioMed Res. Int. 2019, 2019, 1295457.
- Kriaa, M.; Hammami, I.; Sahnoun, M.; Azebou, M.C.; Triki, M.A.; Kammoun, R. Biocontrol of tomato plant diseases caused by Fusarium solani using a new isolated Aspergillus tubingensis CTM 507 glucose oxidase. Comptes Rendus. Biol. 2015, 338, 666–677. [Google Scholar] [CrossRef]
- Jovičić-Petrović, J.; Jeremić, S.; Vucković, I.; Vojnović, S.; Bulajić, A.; Raičević, V.; Nikodinović-Runić, J. Aspergillus piperis A/5 from plum-distilling waste compost produces a complex of antifungal metabolites active against the phytopathogen Pythium aphanidermatum. Arch. Biol. Sci. 2016, 68, 279–289. [Google Scholar] [CrossRef]
- El-Maraghy, S.S.; Tohamy, T.A.; Hussein, K.A. Role of plant-growth promoting fungi (PGPF) in defensive genes expression of Triticum aestivum against wilt disease. Rhizosphere 2020, 15, 100223. [Google Scholar] [CrossRef]
- Verma, P.P.; Shelake, R.M.; Das, S.; Sharma, P.; Kim, J.Y. Plant growth-promoting rhizobacteria (PGPR) and fungi (PGPF): Potential biological control agents of diseases and pests. In Microbial Interventions in Agriculture and Environment; Springer: Singapore, 2019; pp. 281–311. [Google Scholar]
- Yan, P.S.; Song, Y.; Sakuno, E.; Nakajima, H.; Nakagawa, H.; Yabe, K. Cyclo (L-leucyl-L-prolyl) produced by Achromobacter xylosoxidans inhibits aflatoxin production by Aspergillus parasiticus. Appl. Environ. Microbiol. 2004, 70, 7466–7473. [Google Scholar] [CrossRef] [Green Version]
- Hassan, M.A.; El-Saadony, M.T.; Mostafa, N.G.; El-Tahan, A.M.; Mesiha, P.K.; El-Saadony, F.M.; Hassan, A.M.; El-Shehawi, A.M.; Ashry, N.M. The use of previous crops as sustainable and eco-friendly management to fight Fusarium oxysporum in sesame plants. Saudi J. Biol. Sci. 2021, 28, 5849–5859. [Google Scholar] [CrossRef]
- El-Marzoky, H.A.; Abdel-Sattar, M. Influence of growing sweet pepper in compacted rice straw bales compared with natural soil, on infection with pathogenic fungi and nematodes under greenhouse conditions. Arab Univ. J. Agric. Sci. 2008, 16, 481–492. [Google Scholar] [CrossRef]
- Jaber, L.R.; Alananbeh, K.M. Fungal entomopathogens as endophytes reduce several species of Fusarium causing crown and root rot in sweet pepper (Capsicum annuum L.). Biol. Control 2018, 126, 117–126. [Google Scholar] [CrossRef]
- Abdelaziz, A.M.; Dacrory, S.; Hashem, A.H.; Attia, M.S.; Hasanin, M.; Fouda, H.M.; Kamel, S.; ElSaied, H. Protective role of zinc oxide nanoparticles based hydrogel against wilt disease of pepper plant. Biocatal. Agric. Biotechnol. 2021, 35, 102083. [Google Scholar] [CrossRef]
- Rivera-Jiménez, M.N.; Zavaleta-Mancera, H.A.; Rebollar-Alviter, A.; Aguilar-Rincón, V.H.; García-De-Los-Santos, G.; Vaquera-Huerta, H.; Silva-Rojas, H.V. Phylogenetics and histology provide insight into damping-off infections of ‘Poblano’ pepper seedlings caused by Fusarium wilt in greenhouses. Mycol. Prog. 2018, 17, 1237–1249. [Google Scholar] [CrossRef]
- Basco, M.; Bisen, K.; Keswani, C.; Singh, H.B. Biological management of Fusarium wilt of tomato using biofortified vermicompost. Mycosphere 2017, 8, 467–483. [Google Scholar] [CrossRef]
- Orcutt, D.M. The Physiology of Plants Under Stress: Soil and Biotic Factors; John Wiley & Sons: Hoboken, NJ, USA, 2000; Volume 2. [Google Scholar]
- Attia, M.S.; Sharaf, A.E.-M.M.; Zayed, A.S. Protective Action of Some Bio-Pesticides against Early Blight Disease Caused By Alternaria Solani In Tomato Plant. JISET Int. J. Innov. Sci. Eng. Tech. 2017, 4, 67–94. [Google Scholar]
- Hussain, T.; Javed, M.; Shaikh, S.; Tabasum, B.; Hussain, K.; Ansari, M.S.; Khan, A.; Khan, A.A. 4 Enhancement of Plant Secondary Metabolites Using Fungal Endophytes. In Biotechnological Approaches to Enhance Plant Secondary Metabolites; CRC Press: Boca Raton, FL, USA, 2021; pp. 61–70. [Google Scholar]
- Chand, K.; Shah, S.; Sharma, J.; Paudel, M.R.; Pant, B. Isolation, characterization, and plant growth-promoting activities of endophytic fungi from a wild orchid Vanda cristata. Plant Signal. Behav. 2020, 15, 1744294. [Google Scholar] [CrossRef]
- Ismail, A.H.; Mehmood, A.S.I.F.; Qadir, M.U.H.A.M.M.A.D.; Husna, A.I.; Hamayun, M.U.H.A.M.M.A.D.; Khan, N.A.E.E.M. Thermal stress alleviating potential of endophytic fungus rhizopus oryzae inoculated to sunflower (Helianthus annuus L.) and soybean (Glycine max L.). Pak. J. Bot. 2020, 52, 1857–1865. [Google Scholar] [CrossRef]
- Hussain, S.A.; Nazir, Y.; Hameed, A.; Yang, W.; Mustafa, K.; Song, Y. Optimization of Diverse Carbon Sources and Cultivation Conditions for Enhanced Growth and Lipid and Medium-Chain Fatty Acid (MCFA) Production by Mucor circinelloides. Fermentation 2019, 5, 35. [Google Scholar] [CrossRef] [Green Version]
- Bassanezi, R.; Amorim, L.; Filho, A.B.; Hau, B.; Berger, R.D. Accounting for photosynthetic efficiency of bean leaves with rust, angular leaf spot and anthracnose to assess crop damage. Plant Pathol. 2001, 50, 443–452. [Google Scholar] [CrossRef]
- Nogués, S.; Cotxarrera, L.; Alegre, L.; Trillas, M.I. Limitations to photosynthesis in tomato leaves induced by Fusarium wilt. New Phytol. 2002, 154, 461–470. [Google Scholar] [CrossRef]
- Singh, V.K.; Singh, H.B.; Upadhyay, R.S. Role of fusaric acid in the development of ‘Fusarium wilt’symptoms in tomato: Physiological, biochemical and proteomic perspectives. Plant Physiol. Biochem. 2017, 118, 320–332. [Google Scholar] [CrossRef] [PubMed]
- Arfan, M.; Athar, H.R.; Ashraf, M. Does exogenous application of salicylic acid through the rooting medium modulate growth and photosynthetic capacity in two differently adapted spring wheat cultivars under salt stress? J. Plant Physiol. 2007, 164, 685–694. [Google Scholar] [CrossRef] [PubMed]
- Choudhury, S.; Panda, S.K. Toxic Effects, Oxidative Stress and Ultrastructural Changes in Moss Taxithelium Nepalense (Schwaegr.) Broth. Under Chromium and Lead Phytotoxicity. Water Air Soil Pollut. 2005, 167, 73–90. [Google Scholar] [CrossRef]
- Jahan, M.S.; Shah, M.; Shirong, J.; Raziq, G.A.; Sheng, B.S.; Yu, S.; Golam, W.; Khairul, J.A.; Rana, R.K. Melatonin alleviates nickel phytotoxicity by improving photosynthesis, secondary metabolism and oxidative stress tolerance in tomato seedlings. Ecotoxicol. Environ. Saf. 2020, 197, 110593. [Google Scholar] [CrossRef]
- Singh, G.; Tiwari, A.; Gupta, A.; Kumar, A.; Hariprasad, P.; Sharma, S. Bioformulation development via valorizing silica-rich spent mushroom substrate with Trichoderma asperellum for plant nutrient and disease management. J. Environ. Manag. 2021, 297, 113278. [Google Scholar] [CrossRef]
- Anwer, M.A.; Khan, M.R. Aspergillus niger as tomato fruit (Lycopersicum esculentum Mill.) quality enhancer and plant health promoter. J. Postharvest Technol. 2013, 1, 36–51. [Google Scholar]
- Neagu, D.; Leopold, L.F.; Thonart, P.; Destain, J.; Socaciu, C. Enzyme-assisted extraction of carotenoids and phenolic derivatives from tomatoes. Bull UASVM Anim. Sci. Biotechnol. 2014, 71, 20–26. [Google Scholar]
- Dufossé, L. Microbial production of food grade pigments. Food Technol. Biotechnol. 2006, 44, 313–323. [Google Scholar]
- Kour, D.; Rana, K.L.; Yadav, N.; Yadav, A.N.; Singh, J.; Rastegari, A.A.; Saxena, A.K. Agriculturally and Industrially Important Fungi: Current Developments and Potential Biotechnological Applications. In Recent Advancement in White Biotechnology through Fungi; Springer: Cham, Switzerland, 2019; pp. 1–64. [Google Scholar] [CrossRef]
- Al-Ani, R.A.; Adhab, M.A. Bean Yellow Mosaic Virus (BYMV) on Broadbean: Characterization and Resistance Induced by Rhizobium leguminosarum. J. Pure Appl. Microbiol. 2013, 7, 135–142. [Google Scholar]
- Elsharkawy, M.M.; Shivanna, M.B.; Meera, M.S.; Hyakumachi, M. Mechanism of induced systemic resistance against anthracnose disease in cucumber by plant growth-promoting fungi. Acta Agric. Scand. Sect. B—Soil Plant Sci. 2015, 65, 287–299. [Google Scholar] [CrossRef]
- Hossain, M.M.; Sultana, F.; Islam, S. Plant Growth-Promoting Fungi (PGPF): Phytostimulation and Induced Systemic Resistance. In Plant-Microbe Interactions in Agro-Ecological Perspectives; Singh, D., Singh, H., Prabha, R., Eds.; Springer: Singapore, 2017; pp. 135–191. [Google Scholar]
- Shoresh, M.; Harman, G.E.; Mastouri, F. Induced Systemic Resistance and Plant Responses to Fungal Biocontrol Agents. Annu. Rev. Phytopathol. 2010, 48, 21–43. [Google Scholar] [CrossRef] [Green Version]
- Doughari, J. An overview of plant immunity. J. Plant Pathol. Microbiol 2015, 6, 10.4172. [Google Scholar]
- Ramamoorthy, V.; Viswanathan, R.; Raguchander, T.; Prakasam, V.; Samiyappan, R. Induction of systemic resistance by plant growth promoting rhizobacteria in crop plants against pests and diseases. Crop Prot. 2001, 20, 1–11. [Google Scholar] [CrossRef]
- Sakaguchi, S.; Powrie, F. Emerging Challenges in Regulatory T Cell Function and Biology. Science 2007, 317, 627–629. [Google Scholar] [CrossRef]
- Couée, I.; Sulmon, C.; Gouesbet, G.; El Amrani, A. Involvement of soluble sugars in reactive oxygen species balance and responses to oxidative stress in plants. J. Exp. Bot. 2006, 57, 449–459. [Google Scholar] [CrossRef]
- Syed-Ab-Rahman, S.F.; Singh, E.; Pieterse, C.M.J.; Schenk, P.M. Emerging microbial biocontrol strategies for plant pathogens. Plant Sci. 2018, 267, 102–111. [Google Scholar] [CrossRef] [Green Version]
- Sharma, A.; Shahzad, B.; Rehman, A.; Bhardwaj, R.; Landi, M.; Zheng, B. Response of Phenylpropanoid Pathway and the Role of Polyphenols in Plants under Abiotic Stress. Molecules 2019, 24, 2452. [Google Scholar] [CrossRef] [Green Version]
- Lewis, N.G.; Yamamoto, E. Lignin: Occurrence, biogenesis and biodegradation. Annu. Rev. Plant Biol. 1990, 41, 455–496. [Google Scholar] [CrossRef]
- Chávez-Arias, C.C.; Gómez-Caro, S.; Restrepo-Díaz, H. Physiological, Biochemical and Chlorophyll Fluorescence Parameters of Physalis Peruviana L. Seedlings Exposed to Different Short-Term Waterlogging Periods and Fusarium Wilt Infection. Agronomy 2019, 9, 213. [Google Scholar] [CrossRef] [Green Version]
- Moosa, A.; Sahi, S.T.; Khan, S.A.; Malik, A.U. Salicylic acid and jasmonic acid can suppress green and blue moulds of citrus fruit and induce the activity of polyphenol oxidase and peroxidase. Folia Hortic. 2019, 31, 195–204. [Google Scholar] [CrossRef] [Green Version]
- Hassan, N.; Elsharkawy, M.M.; Shivanna, M.B.; Meera, M.S.; Hyakumachi, M. Elevated expression of hydrolases, oxidase, and lyase in susceptible and resistant cucumber cultivars systemically induced with plant growth-promoting fungi against anthracnose. Acta Agric. Scand. Sect. B—Soil Plant Sci. 2014, 64, 155–164. [Google Scholar] [CrossRef]
- Mandal, S.M.; Chakraborty, D.; Dey, S. Phenolic acids act as signaling molecules in plant-microbe symbioses. Plant Signal. Behav. 2010, 5, 359–368. [Google Scholar] [CrossRef] [Green Version]
- Lastochkina, O.; Baymiev, A.; Shayahmetova, A.; Garshina, D.; Koryakov, I.; Shpirnaya, I.; Pusenkova, L.; Mardanshin, I.; Kasnak, C.; Palamutoglu, R. Effects of Endophytic Bacillus Subtilis and Salicylic Acid on Postharvest Diseases (Phytophthora infestans, Fusarium oxysporum) Development in Stored Potato Tubers. Plants 2020, 9, 76. [Google Scholar] [CrossRef] [Green Version]

| Treatment | Disease Symptoms Classes | DI (Disease INDEX) (%) | Protection (%) | ||||
|---|---|---|---|---|---|---|---|
| 0 | 1 | 2 | 3 | 4 | |||
| Control Infected | 0 | 0 | 0 | 3 | 3 | 87.5 a | 0 |
| Infected + A. niger | 3 | 2 | 1 | 0 | 0 | 16.6 e | 81.03 a |
| Infected + A. flavus | 2 | 1 | 1 | 2 | 0 | 37.5 c | 57.14 c |
| Infected + M. circinelloides | 3 | 1 | 2 | 0 | 0 | 20.83 d | 76.19 b |
| Infected + P. oxalicum | 2 | 1 | 1 | 0 | 2 | 45.83 b | 47.62 d |
| Treatments | Total Carbohydrate | Total Phenol | Total Protein | Prolin |
|---|---|---|---|---|
| T1 | 15.03 ± 1.45 f | 0.74 ± 0.08 i | 24.05 ± 2.33 f | 1.33 ± 0.15 f |
| T2 | 28.68 ± 0.64 d | 0.28 ± 0.01 h | 45.88 ± 1.03 d | 0.51 ± 0.03 g |
| T3 | 23.28 ± 0.20 c | 0.96 ± 0.005 g | 51.66 ± 0.32 c | 1.73 ± 0.009 e |
| T4 | 24.96 ± 1.07 e | 1.07 ± 0.01 f | 39.94 ± 1.71 e | 1.93 ± 0.01 d |
| T5 | 37.38 ± 1.86 b | 1.14 ± 0.01 e | 59.97 ± 2.97 b | 1.76 ± 0.02 e |
| T6 | 27.16 ± 0.61 d,e | 1.30 ± 0.03 d | 43.46 ± 0.98 d,e | 2.01 ± 0.05 d |
| T7 | 28.12 ± 0.36 d | 2.06 ± 0.03 c | 44.99 ± 0.58 d | 3.92 ± 0.06 b |
| T8 | 26.08 ± 0.68 d,e | 2.32 ± 0.006 b | 31.72 ± 1.09 d,e | 3.01 ± 0.008 a |
| T9 | 40.12 ± 0.36 a | 1.63 ± 0.03 a | 64.19 ± 0.58 a | 2.12 ± 0.042 c |
| T10 | 28.88 ± 2.28 d | 2.32 ± 0.006 a | 46.20 ± 3.65 d | 3.01 ± 0.008 d |
| LSD at 0.05 | 1.98 | 0.057 | 3.17 | 0.099 |
| RF | 1 | 2 | 3 | 4 | 5 | 6 | 7 | 8 | 9 | 10 | |
|---|---|---|---|---|---|---|---|---|---|---|---|
| POD | 0.416 | + | + | - | + | + | + | + | + | + | + |
| 0.561 | + | + | + | + | + | + | + | + | + | + | |
| 0.783 | ++ | ++ | ++ | +++ | +++ | ++ | ++ | ++ | +++ | +++ | |
| 0.836 | + | ++ | ++ | + | + | + | + | + | + | + | |
| 0.899 | + | + | + | + | + | + | + | + | + | + | |
| PPO | 0.209 | - | - | - | + | - | + | - | - | - | - |
| 0.391 | ++ | ++ | +++ | + | ++ | + | ++ | ++ | ++ | ||
| 0.649 | +++ | +++ | +++ | +++ | + | + | + | + | + | + | |
| 0.715 | ++ | ++ | ++ | +++ | +++ | +++ | ++ | + | ++ | ++ | |
| 0.813 | - | - | + | + | - | - | + | - | ++ | +++ | |
| 0.887 | - | - | - | - | - | - | - | - | + | + | |
Publisher’s Note: MDPI stays neutral with regard to jurisdictional claims in published maps and institutional affiliations. |
© 2022 by the authors. Licensee MDPI, Basel, Switzerland. This article is an open access article distributed under the terms and conditions of the Creative Commons Attribution (CC BY) license (https://creativecommons.org/licenses/by/4.0/).
Share and Cite
Attia, M.S.; Abdelaziz, A.M.; Al-Askar, A.A.; Arishi, A.A.; Abdelhakim, A.M.; Hashem, A.H. Plant Growth-Promoting Fungi as Biocontrol Tool against Fusarium Wilt Disease of Tomato Plant. J. Fungi 2022, 8, 775. https://doi.org/10.3390/jof8080775
Attia MS, Abdelaziz AM, Al-Askar AA, Arishi AA, Abdelhakim AM, Hashem AH. Plant Growth-Promoting Fungi as Biocontrol Tool against Fusarium Wilt Disease of Tomato Plant. Journal of Fungi. 2022; 8(8):775. https://doi.org/10.3390/jof8080775
Chicago/Turabian StyleAttia, Mohamed S., Amer M. Abdelaziz, Abdulaziz A. Al-Askar, Amr A. Arishi, Ahmed M. Abdelhakim, and Amr H. Hashem. 2022. "Plant Growth-Promoting Fungi as Biocontrol Tool against Fusarium Wilt Disease of Tomato Plant" Journal of Fungi 8, no. 8: 775. https://doi.org/10.3390/jof8080775
APA StyleAttia, M. S., Abdelaziz, A. M., Al-Askar, A. A., Arishi, A. A., Abdelhakim, A. M., & Hashem, A. H. (2022). Plant Growth-Promoting Fungi as Biocontrol Tool against Fusarium Wilt Disease of Tomato Plant. Journal of Fungi, 8(8), 775. https://doi.org/10.3390/jof8080775

